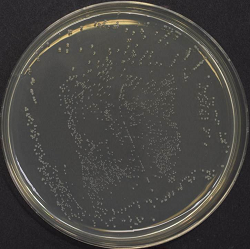
Moraxella osloensis NBRC 111460のプレート写真
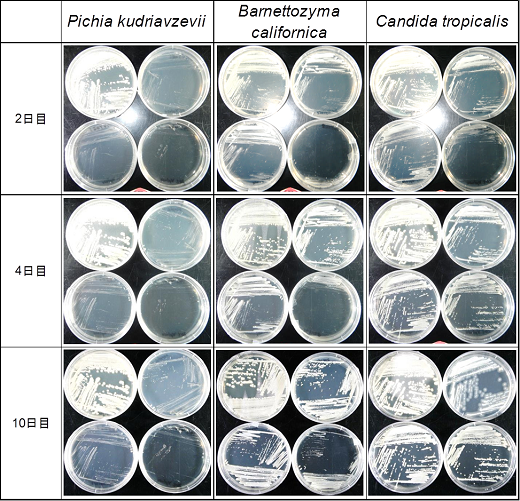
各基質濃度における酵母の生育状況
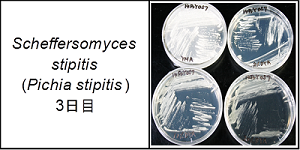
各基質濃度における酵母の生育状況

NBRCニュース 第38号
◆◇◆ ━━━━━━━━━━━━━━━━━━━━━━━━━━━━━━━━ ◆◇◆
NBRCニュース No. 38(2016.3.31)
◆◇◆ ━━━━━━━━━━━━━━━━━━━━━━━━━━━━━━━━ ◆◇◆
NBRCニュース第38号をお届けします。今号は微生物の培養法、微生物あれこれの2つの
連載をお届けします。また新しいサービスや公募などのお知らせがたくさんありますが、
最後までお読みいただければ幸いです。
================================================================================
内容
================================================================================
1.新たにご利用可能となった微生物株
2.微生物あれこれ(34)Moraxella(モラクセラ)属細菌について
3.微生物の培養法(19)キシロース利用酵母の単離
4.インドネシアの国立微生物資源センターInaCCの開業
5.NBRC株の復元培養株分譲の試験運用について
6.平成28年度海外微生物探索に関する共同事業先の公募のお知らせ
7.ゴールデンウィーク期間中のNBRC微生物株・DNAリソースの発送休止について
8.NITEバイオテクノロジーセンター展示のお知らせ
================================================================================
1.新たにご利用可能となった微生物株
================================================================================
◆ NBRC株
酵母 8株、糸状菌 7株、細菌 65株、アーキア 3株が新たにご利用可能となりました。
細菌では、塩素耐性が報告されているMethylobacterium aquaticum NBRC 110153~NBRC
110162および、JIS K 3810-1:2006マイコプラズマの検出法に規定されているMycoplasma
arginini NBRC 111899の分譲を開始しました。M. argininiは、日本薬局方17改正でも規
定される予定です。
酵母では、リクエストの多かった分裂酵母(Schizosaccharomyces pombe)のゲノム解
析株(L972株)を大阪市立大学中村太郎先生のご厚意により寄託いただき、この度公開し
ました。ゲノムDNAもご利用可能です。
糸状菌では一般家庭の浴室バイオフィルムから分離した黒色糸状菌5種5株を公開しまし
た。また、汚染源となる糸状菌の特集ページに約100株の情報を追加しています。
【詳細】 https://www.nite.go.jp/nbrc/cultures/nbrc/new_strain/new_dna.html
【食品汚染・住環境から分離された糸状菌(カビ)】
https://www.nite.go.jp/nbrc/cultures/nbrc/use/emv_fungi.html
◆ RD株
スクリーニング株(RD株)として、沖縄県のマングローブ林等の海洋環境由来のラビリ
ンチュラ類36株を追加いたしました。是非、リストをご覧ください。
【詳細】 https://www.nite.go.jp/nbrc/cultures/rd/new_rd.html
【RD株リスト】 https://www.nite.go.jp/nbrc/cultures/rd/available_rd_list.html
================================================================================
2.微生物あれこれ(34)
Moraxella(モラクセラ)属細菌について (村松由貴)
================================================================================
Moraxella属細菌をご存知ですか? 2011年、花王株式会社のニュースリリース「洗濯後
に発生する衣類の悪臭の原因菌を解明」で、衣類の悪臭の原因菌がMoraxella osloensis
と報告され、この名前を知った方も多いと思います(1)。今回は、Moraxella属のいくつか
の種について、簡単に紹介します。
Moraxellaという属名は、スイスの眼科医Victor Moraxに由来します。基準種は
Moraxella lacunataで、その基準株は結膜炎患者から分離されました。Moraxella属細菌
は、19種知られており、ヒトや動物の口腔・上気道・性器の粘膜における常在菌や病原菌
として知られている種もあります。
例えば、Moraxella catarrhalisは、ヒト呼吸器感染症の原因菌で、子供や乳幼児の中
耳炎や副鼻腔炎の原因菌として知られています。カタル(catarrh)とは、剥離した粘膜
細胞や白血球と粘液の分泌などによる、濃い浸出液を伴う粘膜の炎症のことを言います
が、種小名の「catarrhalis」は、このカタル症状に由来します。臨床現場では、
Branhamella catarrhalisの学名が定着しているそうで、その名前が使われることもあり
ます。
また、Moraxella bovisは、牛の感染症である牛伝染性角結膜炎の原因菌として知られ
ています。「bovis」はラテン語で牛のことで、牛伝染性角結膜炎に感染した牛の眼から
の分離例が一番多いようですが、羊やネズミの眼からも分離されています。
生乾きの臭いの原因菌M. osloensisは、Bovre & Henriksenによって1967年に提案さ
れ、「osloensis」は、M. osloensis の基準株がノルウェーのオスロで分離されたことに
由来します。基準株はヒト脳脊髄液から分離されています。今でこそ食品や環境からの
分離例も報告されており、衣類の生乾きの臭いの原因菌ということでも身近な印象です
が、日和見感染菌としても知られています。
NBRCではM. lacunataとM. osloensisの基準株を保存・分譲しています。

Moraxella osloensis NBRC 111460 のプレート写真
【参考文献】
(1) Kubota, H. et al. (2012). Moraxella species are primarily responsible for
generating malodor in laundry. Appl Environ Microbiol.78(9):3317-3324.
================================================================================
3.微生物の培養法(19)
キシロース利用酵母の単離 (小林隆一)
================================================================================
特定の基質を資化する微生物の分離を試みる場合、その基質が単一炭素源となる培地を
用い、様々な培養条件、例えばpH、温度などの条件を組み合わせると、その条件に見合う
中で多様な微生物を分離することができます。今回は、キシロース利用酵母を探索するた
めの分離方法を説明します。
酵母は従属栄養生物ですから、通常、炭素源と窒素源がなければ増殖できませんが、そ
れらの栄養源は多ければそれだけ多くの酵母が取得できるというものでもありません。主
たる炭素源であるグルコースでは、40%までの濃度なら殆どの酵母が良好に生育しますが、
50~70%の濃度では、一部の種を除き、浸透圧のために生育が阻害されます(1)。
ではこの炭素源を、木質系バイオマスの主成分の一種であるキシランの、主鎖を構成す
る五炭糖のキシロースにするとどうでしょうか?
多くのキシロース資化性及び発酵性酵母種の単離に関する報告では、キシロースを0.5
~2%程度に調製した寒天培地で生育させていますが、他方で20%を超える濃度では生育が
阻害されることが報告されています。
そこで、キシロース濃度を2%、10%及び20%に調整した寒天培地を用いて生育試験を行い
ました。試験に用いた酵母は、1) キシロース資化性が陰性と記載されているPichia
kudriavzevii、2) キシロース資化性が陽性のBarnettozyma californica、3) 同じく陽性
であり、さらに高い資化性能を持つと多数報告されているCandida tropicalis、4) 陽性
でかつ代表的なキシロース発酵種として知られるScheffersomyces stipitis(Pichia
stipitis)、の4種です(2)。資化性を持つ3菌種ではどれも、炭素源がグルコースであるY
M培地(NBRC No. 108培地)やキシロース濃度2%及び10%の試験区では培養1日目からの生
育が確認できるのに対して、20%の濃度では培養2日目まで生育が確認できず、阻害されて
いると考えられました。しかしS. stipitisは培養3日目、C. tropicalisは培養4日目、B.
californicaは培養10日目程度から、キシロース濃度20%でも生育しました(下図参照)。


図:各基質濃度における酵母の生育状況
各区の左上:YM寒天培地(ポジティブコントロール)、右上:2%、左下:10%、
右下:20% D-xylose + 0.67% YNB寒天培地 25℃培養
このように基質濃度を増加させることにより、資化性のある酵母の中でもさらに選択圧
がかかるため、低濃度での分離方法と比べて分離される種に変化が生じると考えられま
す。
この試験においてS. stipitis及びC. tropicalisは高濃度でも比較的良好な生育を示し
ました。このことから、高濃度の基質を含む培地によって、高い資化性を示す種が取得で
きる確率が高まると考えられます。すなわち、20%キシロース培地を用いた分離法は、多
くの酵母が高濃度のキシロースで生育阻害される中、高効率でキシロースを利用できる酵
母だけが選択的に取得できるという、冒頭で説明した一般的な酵母の性質を逆手に取った
手法になるわけです。
またこの手法によって、インドネシアよりS. stipitisや他の高資化性種を分離するこ
とに成功しました。特定の基質資化性を有する微生物の分離を試みる際には、その基質の
濃度を高め、選択圧をかける手法も検討してみてはいかがでしょうか?
この内容の一部は2015年度日本生物工学会で発表しました。
【参考文献】
(1) Kurtzman C. P., Fell J. W., Boekhout T., Robert V. (2011). Methods for
isolation, phenotypic characterization and Maintenance of yeasts.
in The Yeasts, a Taxonomic Study, 5th edn, pp. 87–110.
(2) Payne R. W. et al.(2011). Key to Species. in The Yeasts, a Taxonomic Study,
5th edn, pp.175-277
================================================================================
4.インドネシアの国立微生物資源センターInaCCの開業 (鈴木健一朗)
================================================================================
インドネシア科学研究院(LIPI)は生物学研究センターに微生物資源センターInaCCを
開業しました。NITEが東大、理研と共同で実施した2011年より5年間のSATREPSプロジェク
ト(地球規模課題対応国際科学技術協力プログラム)「生命科学研究及びバイオテクノロ
ジー促進のための国際標準の微生物資源センターの構築」の実施課題の一つとして実現し
たものです。生物多様性条約・名古屋議定書が発効し、生物資源へのアクセスに対する国
家の管理が厳しくなる中、とりわけ途上国の生物資源へのアクセスは困難となっていま
す。InaCCはインドネシアの特徴的な熱帯微生物資源利用のための基盤としてインドネシ
アの研究者だけでなく、海外の研究者の微生物材料の合法的な取得を支援し、国際共同研
究を促進し、論文発表や適切な利益配分に貢献することが期待されます。
また、プロジェクトでは共同研究によりキナアルカロイドを生産する植物、Cinchona
spp.の内生菌、海洋・マングローブ由来の放線菌、油脂生産酵母、五炭糖資化酵母、発酵
食品由来乳酸菌などインドネシアの微生物を対象とした多くの研究課題を実施し、合計で
2,000株を超える微生物をInaCCに寄託登録しました。さらにその一部約700株はNBRCにも
寄託されています。これらの菌株はこれから順次公開していく予定で、研究利用のために
分譲を受けることができます。研究の成果を商業利用したい場合にはInaCCと別途協議す
ることになります。NBRCでは海外由来の微生物株の利活用のために提供国とともに資源の
充実と利用環境の整備を進めています。
【詳細】 http://www.jst.go.jp/global/case/biological_resources_1.html
================================================================================
5.NBRC株の復元培養株分譲の試験運用について
================================================================================
NBRCでは多くの微生物を、L-乾燥保存(ガラスアンプル)や凍結保存(凍結用チュー
ブ)で管理しており、そのままの形態でお客様にお送りし、菌株受領後に復元培養を行っ
ていただいています。
3月から、NBRC番号の付いた菌株を対象に、ご依頼に応じてL-乾燥保存標品等から復元
培養を行い、培養状態にしてからお届けするサービスの試験運用を開始しました。この試
験運用は約1年の期間を設けています。
試験運用期間 2017年2月28日まで
対象微生物 通常の発送形態がL-乾燥標品か凍結融解標品であるNBRC株
発送形態 原則として、試験管(直径16.5×190 mm)の斜面培地に植菌した状態
利用制限 発送先は国内のみ
復元培養のご依頼1件につき、菌株数に関係なく上限5本まで
申込方法 下記URLからダウンロードできる様式を用いて、FAXまたはメール等で
お申し込みください。
価格(税別) (通常の分譲手数料*)+復元培養手数料20,000円/本+送料500円/件
*一般・法人向け 8,000円/本、アカデミック 4,000円/本
割引対象や制限付き、中学高校向け教材などの場合は下記詳細をご覧
ください。
【詳細】 https://www.nite.go.jp/nbrc/cultures/nbrc/order/active_culture.html
================================================================================
6.平成28年度海外微生物探索に関する共同事業先の公募のお知らせ
================================================================================
平成28年度に実施予定の「海外における生物遺伝資源の保全と持続可能な利用に関する
共同事業」に関して微生物探索を現地で行う共同事業先を公募いたします。モンゴルは現
地での微生物探索のラストチャンスです。
詳細は以下をご覧ください。
モンゴル:
https://www.nite.go.jp/nbrc/global/information/collabo_Mongolia_201603.html
ミャンマー:
https://www.nite.go.jp/nbrc/global/information/collabo_Myanmar_201603.html
================================================================================
7.ゴールデンウィーク期間中のNBRC微生物株・DNAリソースの発送休止について
================================================================================
NBRCでは下記のGW期間中、お送りする微生物の品質を確保するため、微生物株・DNAリ
ソースの発送を休止させていただきます。
発送休止期間: 平成28年4月26日(火) ~ 平成28年5月6日(金)
発送予定:
4月22日(金) 午前まで受付分 → 4月25日(月)発送
4月22日(金) 午後~4月28日(木) まで受付分 → 5月 9日(月)発送
4月29日(金) ~5月10日(火) まで受付分 → 5月12日(木)以降、順次発送
発送休止期間中にいただきました分譲依頼につきましては、翌営業日以降に順次対応と
させていただきます。発送予定日につきましては、NBRCからFAXまたはメールにてお送り
している「分譲依頼受領」の案内をご確認ください。
================================================================================
8.NITEバイオテクノロジーセンター展示のお知らせ
================================================================================
以下に出展いたします。また、バイオファーマジャパン2016にてセミナーも開催いたし
ます。ブースではお立ち寄りいただいた皆様からのご相談やご質問にもお答えします。是
非お越しください。
◆ バイオファーマジャパン2016
日程:平成28年4月20日(水)~22日(金)
場所:東京ビッグサイト 東1・2・3ホール (V-13)
http://www.cphijapan.com/info/bioph.html
バイオファーマセミナー「貴重な微生物・細胞の消失リスクから企業を守る
~生物遺伝資源バックアップ保管サービスのご紹介~」
演者:鶴海泰久 ほか
日時:平成28年4月20日(水) 15:00~15:45
場所:東京ビッグサイト 東1ホール内セミナー会場L (L-5)
バイオファーマジャパンの上記URLから事前登録してご来場ください。
◆ 第29回インターフェックス ジャパン
日程:平成28年6月29日(水)~7月1日(金)
場所:東京ビッグサイト
http://www.interphex.jp/
================================================================================
編集後記
================================================================================
暖冬で短かった冬も終わりに近づき、外に出やすくなってきました。弊所がある木更津
市周辺にはゴルフ場がたくさんあります。私は週末になると、神奈川県よりアクアライン
を通ってゴルフをしに行くのですが、これからはアクアラインを通る回数が増えそうで
す。今年は花粉の量が多いので、「飛散」なプレイをしないよう気をつけたいものです。
来年度も是非、本メールマガジン「NBRCニュース」をご愛顧いただきますようお願いい
たします。(TA)
◆◇◆ ━━━━━━━━━━━━━━━━━━━━━━━━━━━━━━━━ ◆◇◆
・画像付きのバックナンバーを以下のサイトに掲載しております。受信アドレス変更、
受信停止も以下のサイトからお手続きいただけます。
https://www.nite.go.jp/nbrc/cultures/others/nbrcnews/nbrcnews.html
・NBRCニュースは配信登録いただいたメールアドレスにお送りしております。
万が一間違えて配信されておりましたら、お手数ですが、下記のアドレスにご連絡く
ださい。
・ご質問、転載のご要望など、NBRCニュースについてのお問い合わせは、下記のアドレ
スにご連絡ください。
・掲載内容は予告なく変更することがございます。掲載内容を許可なく複製・転載され
ることを禁止します。
・偶数月の1日(休日の場合はその前後)に配信します。第39号は2016年6月1日に配
信予定です。
編集・発行
独立行政法人製品評価技術基盤機構(NITE)バイオテクノロジーセンター
NBRCニュース編集局(nbrcnews@nite.go.jp)
◆◇◆ ━━━━━━━━━━━━━━━━━━━━━━━━━━━━━━━━ ◆◇◆
お問い合わせ
-
独立行政法人製品評価技術基盤機構 バイオテクノロジーセンター
生物資源利用促進課
(お問い合わせはできる限りお問い合わせフォームにてお願いします)
-
TEL:0438-20-5763
住所:〒292-0818 千葉県木更津市かずさ鎌足2-5-8 地図
お問い合わせフォームへ